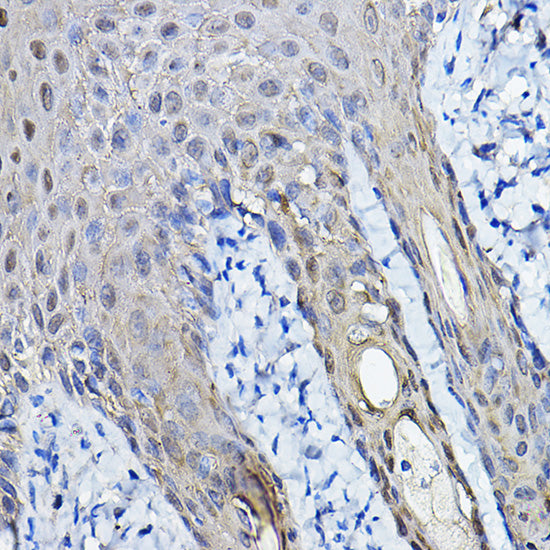

14-3-3 sigma Rabbit pAb
Regular price
$108.00 USD
Sale price
Regular price
Unit price
/per
Shipping calculated at checkout.
Documents
Available in stock (500)
Request a Quote
✅ Thank you! Your quote request was sent successfully.
❌ Something went wrong. Please check your details and try again.
- Customs clearance fees may apply
- Worldwide shipping available.
Couldn't load pickup availability
For research use only — not intended for clinical or diagnostic purposes.
Product Overview
Product Overview
Alternative names
YWHAS; 14-3-3 sigma
Applications
WB, IHC-P, ELISA
Geneid human
2810
Gene id
2810
Host
Rabbit
Protein weight
28kDa
Route
Synthetic peptide|A synthetic peptide corresponding to a sequence within amino acids 1-100 of human 14-3-3 sigma (NP_006133.1).
Shipping conditions
Ice bag
Species
Human, Mouse, Rat
Species reactivity
Human
Swiss
P31947
Background
Background
Primary antibody for 14-3-3 sigma research. Host: Rabbit. Applications: WB, IHC-P, ELISA. Reactivity: Human. For research use only.
Documents
Documents
Documents
Product Citations
Product Citations
More Info
More Info

14-3-3 sigma Rabbit pAb
Regular price
$108.00 USD
Sale price
Regular price
Unit price
/per



